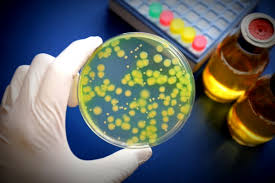

티스토리 뷰
목차
겨울이면 많은 사람들이 즐겨 먹는 굴. 특히 김장철과 맞물려 많은 분들이 김치, 보쌈과 함께 생굴을 즐겨드시곤 하는데요. 이처럼 굴의 수요가 늘어나는 만큼 노로바이러스 환자도 함께 증가하는 추세예요.
질병관리청에 따르면 최근 한 달 새 노로바이러스 감염증이 2배 이상 발생했다고 해요. 최근 3년 간의 데이터를 보면 12월~1월 사이에 감염된 경우가 가장 많기도 하고요.
최대한 노로바이러스에 감 염되지 않도록 노로바이러스 원인부터 구체적인 예방법까지 꼼꼼하게 정보 알려드릴게요.



노로바이러스 원인이 무엇인가요?
노로바이러스는 위와 장에 염증을 일으키는, 크기가 매우 작은 바이러스인 노로바이러스에 감염되어 일어나는 식중독을 의미해요. 겨울철 식중독의 대표적인 원인균으로, 오염된 ①식품과 물을 가열하지 않고 섭취했거나 제대로 ②익히 지 않은 어패류나 생선을 먹었을 때 감염되는 경우가 많아요.
또한 노로바이러스에 걸린 ③사람을 통해 옮기도 해요. 소량의 바이러스만으로도 감염될 수 있을 정도로 전염성이 높고 사람에서 사람으로 쉽 게 퍼지는 특성을 갖고 있어요.
• 바이러스별검출율[2019~2023]
![바이러스별검출율[2019~2023]](https://blog.kakaocdn.net/dna/TBHr7/btsL3y3mOpA/AAAAAAAAAAAAAAAAAAAAAOAdKFzFPKbVwuDYyzYOlLS7wjPJnTHPFL6N8xggTyCe/img.png?credential=yqXZFxpELC7KVnFOS48ylbz2pIh7yKj8&expires=1761922799&allow_ip=&allow_referer=&signature=apxzt0NskWXHzzNYhJIf%2Bbv86xs%3D)
노로 바이러스 증상이 궁금해요
보통 하루에서 이틀 정도 잠복기를 거쳤다가 설사, 구토, 오한 등의 증세가 나타나는 편이에요. 근육통, 권태, 두통, 발열 등을 유발하기도 하는데 코로나19와 증상이 유사해 정확한 자가진단이 어려운 경우도 많아졌다고 해요.
①소아는 구토가 흔하게 나타나고 ②성인은 설사가 흔한데요. 설사의 경우 물처럼 묽지만 피가 섞이거나 점액이 보이지는 않아요. 설사가 심한 경우는 탈수 증세와 더불어 전해질 불균형이 나타날 수 있어 수분 섭취가 매우 중요해요.
물이나 이온 음료를 마셔주는 것도 도움이 되지만 이온음료를 너무 많이 마실 경우 오히려 설사를 유 발할 수 있으니 적당히 마시고 ①설탕이 많이 들어간 음료나 ②탄산음료, 과일주스는 반드시 피해 주는 게 좋아요.
장이 완전히 회복될 때까지는 밀가루나 자극적인 음식, 기름진 음식은 제한해 주고 죽이나 부드러운 음식으로 섭취하는 걸 권유드려요.



예방은 어떻게 하나요?
1. 철저한 손 씻기
노로바이러스 감염은 손을 통해 이루어지는 경우가 많기 때문에 철저한 손 씻기가 매우 중요하다고 해요. 화장실 사용 후, 기저귀 교체 후, 식사 전 또는 음식 준비 전에는 반드시 손을 깨끗이 씻어주세 요. 손가락 사이사이는 물론 손등까지 골고루 비누를 사용하여 흐르는 물로 20초 이상 씻어야 해요.
2. 배변 후 변기 뚜껑 닫고 물 내리기
질병관리청에서는 노로바이러스 예방을 위해 반드시 변기 뚜껑을 닫고 물을 내려야 한다고 권고하고 있는데요. 그 이유는 노로바이러스가 오염된 음식이나 물, 감염된 사람의 분변이나 구토물에 의해 전염되기 때문이에요. 따라서 변기 물을 내릴 때 튀는 물방울로도 쉽게 전염될 수 있어요. 노로바이 러스 환자의 구토물이나 분변 1g에는 바이러스 입자가 1억 개 정도 들어 있는데 단 10개 만으로도 전염될 만큼 매우 전염이 빠르다고 하니, 공중화장실을 이용할 땐 반드시 참고해 주세요.

3. 과일과 채소 깨끗하게 씻기
과일이나 채소는 흐르는 물에 깨끗하게 씻어야 바이러스 균을 깔끔하게 제거할 수 있어요. 반드시 세 척 후 섭취해 주세요.
4. 굴과 같은 어패류는 꼭 익혀 먹기
굴, 조개, 생선 등 어패류는 반드시 꼭 익혀서 먹어 주세요. 또는 너무 과다 섭취하지 않도록 주의를 기울여 주시면 좋아요.
5. 끓여 마시기
지하수를 식수로 사용하는 경우에도 반드시 끓여 마시기 겨울이라고 안심하지 말고 지하수를 식수로 사용한다면 반드시 펄펄 끓여서 마셔 주세요. 물을 통해 노로바이러스에 걸리는 경우도 생각보다 많은 편이에요.

노로바이러스 빠른 진료 방법
비대면 진료
이제, 누구나 노로바이러스나 장염으로 비대면 진료를 받을 수 있어요. 2024년 2월 23일부터 전면 허용된 비대면 진료 시범사업 보완방안에 따르면, 누구나 365일 24시간 내내 비대면 진료 이용이 가능해요. 조건이나 시간 제약 없이 가능하므로 노로바이러스로 비대면 진료가 필요하다면 아래 버 틀을 눌러보세요.
닥터나우 - 대한민국 1위 비대면진료 앱
비대면진료 어플 닥터나우로 언제든 원격진료 가능! 탈모약, 소아과약, 여드름약도 비대면 약처방 가능해요. 문 연 약국 찾기, 약 배송도 이용해 보세요. - 아플 땐 나우, 닥터나우 *2024 주간동아
doctornow.co.kr
비대면 진료 이용방법
비대면 진료 이용 방법은 매우 간단해요. 비대면 진료 1위 어플 '닥터나우'를 다운로드하고 아래의 4가지 단계를 따라 하기만 하면, 집에서도 간편하게 비대면 진료가 가능해요.
①일요일에도, 밤 8시에도 누구나 쉽게 ②비대면 진료를 이용할 수 있고 노로바이러스③약 처방까지 받을 수 있어 간편해요.

1. 비대면 진료 1위 어플 '닥터나우' 다운로드
2. 메인 화면 '비대면 진료' 탭에서 " 선택
3. 원하는 의사에게 진료 예약 후 전화 · 화상 진료 시작
4. 처방전 발급 후, 약국에 직접 방문해 처방약 수령

비대면 질료 후 약처방은?
노로바이러스로 비대면 진료를 받고 나면 이후에 노로바이러스약 처방을 함께 받을 수 있어요. 기존에 가능했던 '약 배달' 서비스는 섬, 벽지 주민과 감염병으로 인해 격리 중인 환자나 이동이 어려운 장애인 등 매우 드문 환자에게만 적용되기 때문에 처방약을 집으로 배달받는 건 어려워요.
이와 같이 약 배송 서비스는 현재 이용이 어렵지만, 약 처방은 가능하기 때문에 진료가 끝나면 근처 약국에서 노로바이러스 처방약을 받아오기만 하면 돼요.



비대면 진료 후 약 받는 방법?
1. 비대면 진료 후, 처방전 보낼 약국 선택하기
2. 선택한 약국에 전화해 처방약 재고 확인하고 처방전 보내기
3. 해당 약국을 방문해 처방약 받아오기



비대면으로 진료부터 약 받기까지
"비대면 진료 받고 약 처방도 되나요?" 비대면 진료 어플로 약 처방받는 방법
비대면 진료 받고 약 처방도 받을 수 있는지 궁금했다면? 비대면 진료 어플로 약 받는 방법에 대해 알려드릴게요.
doctornow.co.kr
노로바이러스로 비대면 진료와 비대면 약 처방이 필요하다면, 아래 버튼을 클릭해 간편하게 비대면 진료받아보세요. 원하는 시간에 진료를 예약하면 의사 선생님께 전화가 오면서 비대면 진료가 바로 시작돼요. 더 이상 병원에서 오래 기다릴 필요 없어요.



자주 묻는 질문
Q: 비대면 진료는 누구나 가능한가요?
A: 네, 가능해요! 2024년 2월 23일에 시행된 '비대면 진료 시범사업 지침 개정안 공고'에 따르면, 누구나 365일 24시간 내내 비대면 진료를 이용할 수 있어요. 단, 의사의 판단에 따라 비대면 진료가 어려운 증상의 경우 진료가 취소될 수 있어요.
※ 비대면 진료 시범사업 지침 개정안 공고(보건복지부 공고 제2024-239호)
Q: 비대면 진료는 화상으로만 진행되나요?
A: 비대면 진료는 화상진료 또는 음성진료 모두 가능해요. 원하는 방식을 선택해 비대면 진료받아보세요.
Q: 비대면 진료 후 처방전은 어떻게 받을 수 있나요?
A: 비대면 진료가 끝나고 처방전을 받았다면, 해당 처방전을 전송할 약국을 선택해 달라는 화면이 노출돼요.
[앱으로 접수]
'앱으로 접수' 배지가 붙은 약국은 닥터나우 제휴 약국으로, 따로 전화할 필요 없이 앱으로 처방전을 보내면 약 조제가 바로 시작되는 약국이에요.
[전화로 접수]
닥터나우와 제휴하지 않는 약국에도 처방전을 보내고 약을 픽업해 올 수 있어요. 처방전을 보내기 전에 해당 약국에 전화한 후, 처방약의 조제 가능 여부를 확인하고 처방전을 전송하면 돼요.
※ 근처 약국이 보이지 않는 경우 지도의 줌/아웃 기능을 이용해 위치를 변경한 후, [이 위치 재검색]을 누르면 더 많은 약국을 조회할 수 있어요.
※ 닥터나우 앱을 통해 전송되는 처방전은 병원 전산 시스템과 연동된 처방전 원본이에요.
노로바이어스 동영상[어린이조심하세요]
Q: 처방전 다운로드 또는 출력이 가능한가요?
A: 아니요. 현재 보건복지부 시범사업안에 따라, 비대면 진료 후 발급된 처방전은 위·변조 방지를 위해 원본을 다운로드하거나 출력할 수 없어요. 닥터나우 앱을 통해 약국에 처방전을 보내면 복지부 가이드에 맞춰 팩스가 자동 전송돼요. 따라서, 처방전을 따로 출력해 약국에 가져가지 않아도 처방약을 받을 수 있어요.
Q: 비대면 진료로 어떤 약이든 처방받을 수 있나요?
A: 보건복지부 시범사업안에 따라 마약류, 오·남용 의약품, 사후피임약은 비대면 진료를 통해 처방받을 수 없어요. 보다 자세한 내용이 궁금하다면 아래 문서를 확인해 주세요.
✏️「마약류 관리에 관한 법률」제18조 제2항, 제21조 제2항에 따라 마약 및 향정신성 의약품으로 수입·제조허가를 받은 의약품 ※「오·남용 우려 의약품 지정에 관한 규정」(식약처) 지정 품목(23개 품목(성분) 함유제제) ※ 사후피임약 : 레보노르게스트렐(0.75mg, 1.5mg), 울리프리스탈(30mg) 함유제제 [비대면진료 처방제한 의약품]
함께 알아보기
겨울철 감염병 노로바이어스 증상 치료 예방법
노로바이러스는 가장 흔하면서도 과소평가된 건강 위협하는 질병 중 하나이며, 특히 겨울철에 그렇습니다. 이 전염성이 매우 강한 바이러스는 오염된 음식, 물, 표면, 심지어 사람과 사람 간의
woori.ssugaengi.com
휴일 명절(추석,설날) 약국 병원 30초 찾는 방법
휴일이나 명절 때 갑작스러운 사고나 다쳤을 때 대부분의 병원이나 약국이 쉬고 문 여는 곳을 찾으려다보면 어려움을 겪기도 합니다. 지금부턴 그러지 않으시도록 여기 그 사이트와 앱등 휴일
woori.ssugaengi.com
2024 독감 예방 무료 접종 대상 일시 장소
2024년 독감 예방 접종의 시기가 왔나 보네요. 독감예방 무료 접종 그리고 대상, 일시, 장소등을 자세히 알려드리겠습니다. 올해 추석은 유난히 덥지 않았나요? 주말부터는 폭염이 끝나고 가을
ssugaengi.com

